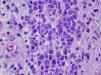
fig0015

A 55-year-old man with a history of neurofibromatosis type 1, adrenal pheochromocytoma, primary hypothyroidism (treated with levothyroxine replacement therapy), and chronic myelomonocytic leukemia (diagnosed in 2005 and being treated with azacytidine) presented with an asymptomatic, rapidly growing right pretibial skin lesion that had appeared 2 months earlier.
Physical ExaminationThe patient had a nonsuppurative ulcer measuring several centimeters in diameter with a purple border. Granulation tissue and a central yellowish membrane were observed (Fig. 1).
HistopathologyA skin biopsy revealed a monomorphic infiltrate of large cells with abundant eosinophilic cytoplasm and prominent nuclei (Figs. 2 and 3). Biopsy cultures were positive for Pseudomonas aeruginosa and methicillin-resistant Staphylococcus aureus.
What Is Your Diagnosis?
DiagnosisSkin infiltration due to chronic myelomonocytic leukemia (leukemia cutis).
Clinical Course and TreatmentThe ulcer continued to grow rapidly, penetrating muscle and bone. The patient was referred to the hematology department and underwent palliative chemotherapy with cytarabine and azacytidine. The disease continued to progress, however, and the patient died 2 months later.
CommentLeukemia cutis is a nonspecific term that refers to a skin infiltration caused by any type of leukemia (myeloid or lymphoid).1 Myeloid sarcoma, primary extramedullary leukemia, or chloromas may be diagnosed in the presence of granulocytic precursors; monocytic precursors, however, indicate monoblastic sarcoma. Leukemia cutis usually develops in patients with systemic disease, but in aleukemic forms, which account for fewer than 10% of cases, skin lesions precede bone marrow or peripheral blood disease.
Chronic myeloproliferative disorders and lymphoproliferative disorders have been described in patients with acute myeloid leukemia (AML). These disorders occur more frequently in AML (in 10%–15% of patients), and the incidence can be as high as 50% in monocytic and myelomonocytic subtypes.2,3 Leukemia cutis is less common in chronic forms of leukemia; when present, it indicates blastic transformation and is therefore a sign of disease progression. These lesions occur more frequently in children and can appear in 25%–30% of congenital leukemia cases.4
The clinical presentation of leukemic skin infiltration is nonspecific and may include single or multiple lesions in the form of papules, plaques, or violaceous nodules that vary in size and usually appear on the lower limbs, head, and neck. Oral mucosal petechial lesions and infiltration of the gums,5 leonine facies, eczematous lesions, genital ulcers, and panniculitis simulating erythema nodosum6 are less common. In children it is one of the causes of blueberry muffin baby syndrome.4
The most frequent skin manifestations, developing in approximately 40% of patients with leukemia, are leukemids or nonleukemic skin disorders, which are attributable to cytopenia or reactions to medication. These lesions present as purpura (petechiae or ecchymosis), leukocytoclastic vasculitis, neutrophilic dermatosis, and opportunistic infections.
A differential clinical diagnosis for leukemia cutis must rule out skin infections related to immune system compromise, nonlymphatic tumor metastasis, Jessner lymphocytic infiltration, and adnexal tumors. A definitive diagnosis is based on histologic findings.1
The histopathology of leukemia cutis shows a perivascular and periadnexal infiltrate or a dense and diffuse interstitial infiltrate that does not affect the epidermis. In myeloid leukemia this infiltrate is composed of large cells with abundant eosinophilic cytoplasm, large nuclei, and small nucleoli. Abundance of mitotic figures may be observed. Neural, adnexal, and muscle structures are rarely involved.
Leukemia cutis is a local manifestation of an underlying condition, which must therefore be the target of curative treatment. Treatment options include systematic chemotherapy along with specific treatment of the leukemia cutis (surgical removal, psoralen-UV-A, topical nitrogen mustard, and daclizumab).6 The prognosis is poor, the disease is aggressive, and the rate of survival is low (1-year survival, <10%).
Conflict of InterestThe authors declare that they have no conflicts of interest.
Please cite this article as: Toledo-Alberola F, Guijarro-Llorca J. Úlcera de rápido crecimiento en paciente con neurofibromatosis tipo 1. Actas Dermosifiliogr. 2012;103:63–4.